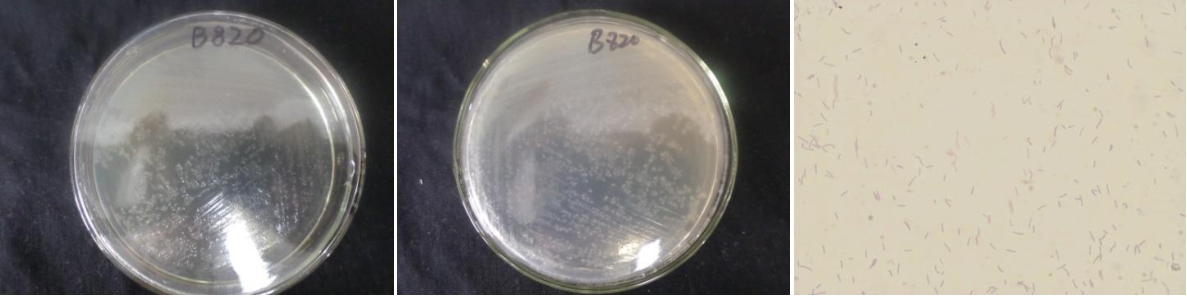

Loading...
| StrainNO | B820 |
| Classification | Paenibacillus |
| 16s rDNA sequence | ATGCAAGTCGAGCGGACTTGATGGAGTGCTTGCACTCCTGATGGTTAGCGGCGGACGGGTGAGTAACACGTAGGCAACCTGCCCT CAAGACTGGGATAACTACCGGAAACGGTAGCTAATACCGGATAATTTATTTCACAGCATTGTGGAATAATGAAAGACGGAGCAAT CTGTCACTTGGGGATGGGCCTGCGGCGCATTAGCTAGTTGGTGGGGTAACGGCCCACCAAGGCGACGATGCGTAGCCGACCTGAG AGGGTGAACGGCCACACTGGGACTGAGACACGGCCCAGACTCCTACGGGAGGCAGCAGTAGGGAATCTTCCGCAATGGGCGAAAG CCTGACGGAGCAACGCCGCGTGAGTGATGAAGGTTTTCGGATCGTAAAGCTCTGTTGCCAAGGAAGAACGTCTTCTAGAGTAACT GCTAGGAGAGTGACGGTACTTGAGAAGAAAGCCCCGGCTAACTACGTGCCAGCAGCCGCGGTAATACGTAGGGGGCAAGCGTTGT CCGGAATTATTGGGCGTAAAGCGCGCGCAGGCGGTTCTTTAAGTCTGGTGTTTAAACCCGAGGCTCAACTTCGGGTCGCACTGGA AACTGGGGAACTTGAGTGCAGAAGAGGAGAGTGGAATTCCACGTGTAGCGGTGAAATGCGTAGATATGTGGAGGAACACCAGTGG CGAAGGCGACTCTCTGGGCTGTAACTGACGCTGAGGCGCGAAAGCGTGGGGAGCAAACAGGATTAGATACCCTGGTAGTCCACGC CGTAAACGATGAATGCTAGGTGTTAGGGGTTTCGATACCCTTGGTGCCGAAGTTAACACATTAAGCATTCCGCCTGGGGAGTACG GTCGCAAGACTGAAACTCAAAGGAATTGACGGGGACCCGCACAAGCAGTGGAGTATGTGGTTTAATTCGAAGCAACGCGAAGAAC CTTACCAAGTCTTGACATCCCTCTGAATCCTCTAGAGATAGAGGCGGCCTTCGGGACAGAGGTGACAGGTGGTGCATGGTTGTCG TCAGCTCGTGTCGTGAGATGTTGGGTTAAGTCCCGCAACGAGCGCAACCCTTGATTTTAGTTGCCAGCACATGATGGTGGGCACT CTAGAATGACTGCCGGTGACAAACCGGAGGAAGGCGGGGATGACGTCAAATCATCATGCCCCTTATGACTTGGGCTACACACGTA CTACAATGGCTGGTACAACGGGAAGCGAAGCCGCGAGGTGGAGCCAATCCTATAAAAGCCAGTCTCAGTTCGGATTGCAGGCTGC AACTCGCCTGCATGAAGTCGGAATTGCTAGTAATCGCGGATCAGCATGCCGCGGTGAATACGTTCCCGGGTCTTGTACACACCGC CCGTCACACCACGAGAGTTTACAACACCCGAAGTCGGTGGGG |
| Strain Morphology Photos | |
| Morphological Description | Colony round;Lychee flesh white;edge serrated;Slightly concave in the middle;multifold;slippy;sticky;thin;translucent;Rod;having spore;Mesophilic budding spore |